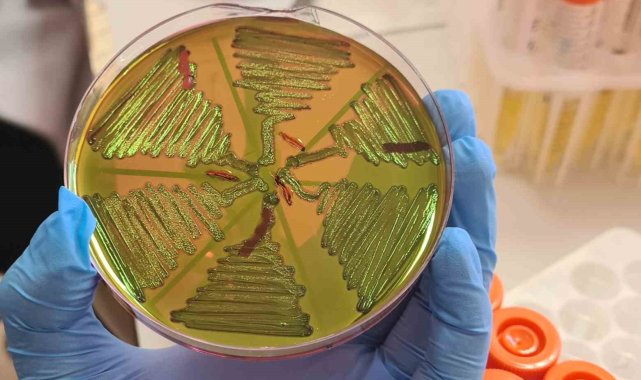

İnönü Üniversitesi Fen-Edebiyat Fakültesi Biyoteknoloji Anabilim Dalı tarafından çiğ süt üzerine yapılan çalışma, görünmez bir bakteri ekosistemini ortaya koydu. Yapılan çalışma, süt aracılığıyla vücuda giren bu sistemdeki bakteriler sessizce üriner sisteme ulaşıp enfeksiyon oluşturuyor.Malatya kırsalından alınan 122 çiğ süt örneğini inceleyen bilim insanları, bazı bakterilerin süt yoluyla vücuda girdiğini ve özellikle kadınlar, yaşlı bireyler ve bağışıklığı zayıf kişiler için risk taşıdığını ortaya koydu.Bilimsel Araştırma Projeleri (BAP) Birimi tarafından desteklenen 'Çiğ Süt Örneklerinde Escherichia coli Prevalansının ve Üropatojenik E. coli (UPEC) Virülans Genlerinin Araştırılması' çalışması Malatya bölgesinden toplanan sütlerde 'E.coli' bakterisinin yüksek oranda bulunduğunu gösterdi.Araştırmanın yürütücüsü Doç. Dr. Seval Cing Yıldırım, bu durumun insan sağlığı açısından risk oluşturduğunu belirtti.Doç. Dr. Seval Cing Yıldırım, "Bugün burada paylaşacağımız emareler, çiğ sütle ilgili bildiklerimizi önemli ölçüde değiştirecek nitelikte. Yıllardır çiğ süt genellikle sadece E. coli var mı yok mu? diye değerlendirildi. Oysa bizim yaptığımız çalışma, çok daha kritik bir noktayı gösteriyor. Bu bakterilerin hangi hastalık yapıcı genleri taşıdığını bilmekte çok önemli. Malatya bölgesinden topladığımız çiğ sütlerde E. coli oranları beklediğimizden yüksekti. Ancak asıl çarpıcı olan şu, bu izolatların önemli bir kısmı, idrar yolu enfeksiyonlarına neden olabilen UPEC (Üropatojenik E. coli) adlı özel suşların genetik özelliklerini taşıyordu. Özellikle 'fimA ve agn43' genleri neredeyse tüm izolatlarda pozitifti. Bu genler bakteriye idrar yollarına tutunma, biyofilm oluşturma ve bağışıklıktan kaçma gibi güçlü yetenekler kazandırıyor" dedi.Çiğ sütün, yalnızca dışkı bulaşıyla kirlenmiş bir ürün olmadığını belirten Doç. Dr. Yıldırım, "Çiğ süt, hastalık yapma potansiyeli yüksek bakteriler için bir taşıyıcı ortam olabilir. Yani çiğ süt, görünmez bir bakteri ekosistemi aslında ve bu ekosistemdeki bazı üyeler insan sağlığı açısından risk oluşturur. Bu durum literatürde giderek önem kazanan bir kavramı işaret ediyor. Yani gıdayla bulaşan idrar yolu enfeksiyonları. Süt aracılığıyla alınan bu bakteriler sessizce üriner sisteme ulaşıp enfeksiyon oluşturabilirler. Özellikle bu durum kadınlarda, yaşlı bireylerde ve bağışıklığı zayıf kişiler için de risk oluşturuyor" ifadesine yer verdi.Bu çalışmanın, Türkiye'deki gıda güvenliği politikaları açısından önemli bir boşluğu da görünür kıldığını vurgulayan Doç. Dr. Yıldırım, "Mevcut denetim sistemleri hâlâ "bakteri var mı yok mu?" yaklaşımına dayalı olarak işliyor. Oysa emarelerimiz, moleküler patojenite analizlerinin ve antimikrobiyal direnç taramalarının rutin gıda kontrol süreçlerine entegre edilmesi gerektiğine işaret etmektedir. Bir diğer kritik emaremiz, tüm izolatların sefalotin antibiyotiğine dirençli olmasının yanı sıra çoklu antibiyotik direnci de mevcut. Bu tablo, antibiyotik direncinin hayvancılık ortamlarında seçilip gıda zinciri aracılığıyla topluma geri döndüğünü açıkça ortaya koyuyor. Başka bir ifadeyle, çiftlikten sofraya uzanan çok yönlü bir direnç zinciri ile karşı karşıyayız" şeklinde konuştu.Isıl işlemin bakteri üzerindeki etkisini de anlatan Doç. Dr. Yıldırım, "Pastörizasyon ve kaynatma büyük oranda etkilidir; ancak sağımdan depolamaya, taşımadan işleme ve satışa kadar uzanan hijyen zinciri doğru işletilmezse risk maalesef sıfırlanmaz. Özellikle çiğ sütten yapılan peynirlerde uygulanan ısıl işlemler kısa süreli olduğu ve yeterli sıcaklığa ulaşmadığı için, dirençli bakterileri ve virülans genlerini tamamen elimine etmek her zaman mümkün değildir. Sonuç olarak, sütün doğal niteliği tek başına mikrobiyolojik güvenliği garanti etmez. Hedefimiz toplumda korku oluşturmak değil, bilimsel kanıtlarla desteklenen bir farkındalık oluşturmaktır. Uygun ısıl işlem, hijyen ve moleküler denetim süreçleri benimsendiğinde süt ve süt ürünlerinin güvenli tüketimi kolayca sağlanabilir" ifadesine yer verdi.6 ayda 122 çiğ süt örneği incelendiAraştırmada yer alan İnönü Üniversitesi yüksek lisans öğrencisi Aynur Akan ise, Malatya kırsalından alınan 122 adet çiğ süt örneğini 6 aylık bir periyotta toplandıklarını söyledi. Proje kapsamındaki çalışmaların bir kısmının Sinop Üniversitesi'nde yürütüldüğünü belirten Akan, "Çalışmaların bir kısmı İnönü Üniversitesi Fen Edebiyat Fakültesi Biyoloji Bölümü Endüstriyel Biyoteknoloji araştırma Laboratuvarı'nda gerçekleştirilirken bir kısmı da Sinop Üniversitesi Öğretim Üyeleri Doç. Dr. Zeynep Yeğin ve Dr. Öğr. Üyesi Cumhur Avşar ile yapıldı. Bilimsel Araştırma Projeleri Birimi'ne desteklerinden ötürü teşekkür ederim" diye konuştu.
Gündem
Yayınlanma: 28 Kasım 2025 - 10:16
Güncelleme: 28 Kasım 2025 - 11:08
Çiğ süt, gıdayla bulaşan idrar yolu enfeksiyonlarına kapı açıyor
İnönü Üniversitesi Fen-Edebiyat Fakültesi Biyoteknoloji Anabilim Dalı tarafından çiğ süt üzerine yapılan çalışma, görünmez bir bakteri ekosistemini ortaya koydu. Yapılan çalışma, süt aracılığıyla vücuda giren bu sistemdeki bakteriler sessizce üriner sisteme ulaşıp enfeksiyon oluşturuyor.
Gündem
28 Kasım 2025 - 10:16
Güncelleme: 28 Kasım 2025 - 11:08
İlginizi Çekebilir